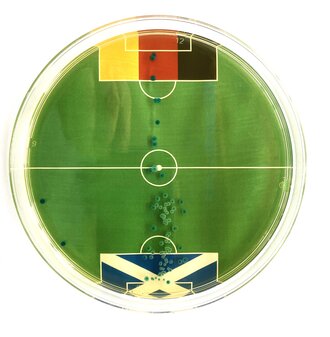

Treffsicher: Die Bakterien sagten bereits den ersten Sieg gegen Schottland goldrichtig voraus.
Professor Egert und die Bakterien-Vorhersage der EM-Ergebnisse
Prof. Dr. Markus Egert, Mikrobiologe an der Hochschule Furtwangen, sorgt mit seinem zur EM erdachten Bakterien-Orakel für medialen Wirbel. Fernseh- und Radiosender, Zeitungen und Onlineplattformen berichten über seine nicht ganz ernst gemeinten Fußballvorhersagen – die allerdings mit einer erstaunlichen Treffsicherheit verblüffen.
Bislang lagen die Bakterien mit ihren Vorhersagen dreimal (gegen Schottland, Ungarn und die Schweiz) goldrichtig. Die Experten der ARD-Sportschau haben das Furtwanger EM-Orakel sogar zu ihrem Redaktionsfavoriten erklärt. (Nachzulesen unter: Nach zweitem Deutschland-Spiel: Acht EM-Orakel weiter fehlerfrei | sportschau.de).
Inspiriert wurde Fußballfan Egert von früheren unterhaltsamen Orakeln wie etwa einem Oktopus, der Fußballergebnisse „vorhersagte“. „Man darf mit der eigenen Forschungsdisziplin auch mal ein bisschen Spaß haben“, sagt Egert, der als führender Hygieneprofessor in Deutschland ansonsten unter anderem Studien zur Keimbelastung von Haushaltsgegenständen führt. Für sein Orakel werden einige wenige Keime sehr gleichmäßig auf einer Nährlösung in einer Petrischale mit aufgebrachtem Spielfeld verteilt. Nach einigen Stunden im Brutschrank kann das Wachstum der Keime genau beobachtet werden – in Form von Punkten, die dann in den beiden Spielhälften zu sehen sind.
„Das große Interesse an unserem Orakel freut mich sehr“, sagt Markus Egert. „Ein großer Dank daher auch meine - leider eher kamerascheuen - Mitarbeiterinnen Nadja Schwendenmann und Anne Proß. Wir werden auf jeden Fall weitermachen!“.
Die Vorhersagen werden regelmäßig auf den social media-Kanälen der HFU veröffentlicht.